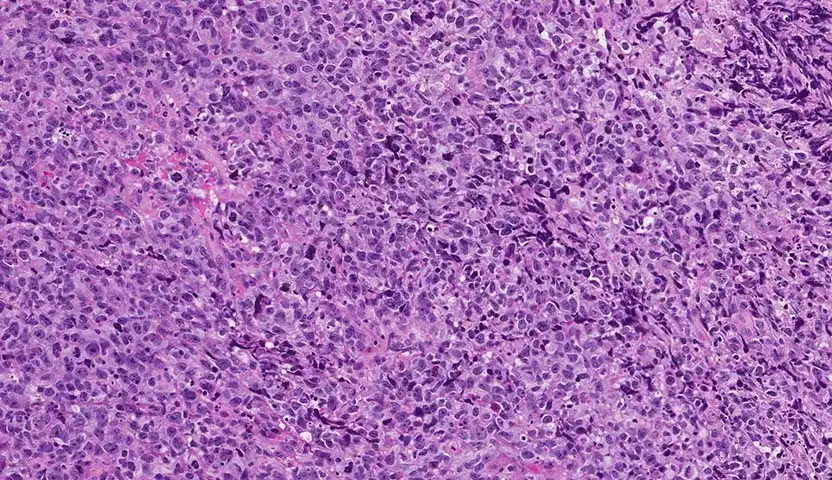

مقالات
اطلع على أحدث المقالات والأبحاث حول علاج أمراض الدم والأورام من خلال خبراءنا المتخصصين.
- حميع المقالات
- Uncategorized
- السرطان الأمبولي
- سرطان الأمعاء الدقيقة
- سرطان البروستاتا
- سرطان البلعوم الأنفي
- سرطان البنكرياس
- سرطان الثدي
- سرطان الجلد
- سرطان الخلايا الحرشفية
- سرطان الدم
- سرطان الغدة الدرقية
- سرطان الغدد الليمفاوية
- سرطان الفم والحلق
- سرطان القناة الصفراوية
- سرطان القولون
- سرطان اللسان
- سرطان المثانة
- سرطان المهبل
- للأطباء
- للمريض

سرطان الخلايا الحرشفية في الفم
يعد سرطان الخلايا الحرشفية في الفم واحد من الأنواع الشائعة لسرطانات الرأس والعنق، والذي يبدأ في الخلايا المسطحة التي تبطن السطح الداخلي للفم، ويمثل تهديدًا […]

سرطان الخلايا الحرشفية في الرئة
يعد سرطان الخلايا الحرشفية في الرئة واحد من أكثر السرطانات الرئوية انتشارًا، والذي غالبًا ما يبدأ ببطانة الشعب الهوائية، ثم يتطور مسببًا بعض الأعراض التي […]

سرطان الخلايا الحرشفية في الأنف
ابيئة حولنا بها الكثير من مسببات الأمراض، وخصوصًا أمراض السرطان المختلفة، وعلى وجه التحديد سرطان الخلايا الحرشفية في الأنف، فالجلد بشكل عام من أكثر الأعضاء […]

سرطان الخلايا الحرشفية في الجلد
سرطان الخلايا الحرشفية في الجلد هو واحد من أنواع السرطان الشائعة، حيث يصاب به أكثر من مليون و800 ألف شخص كل عام في الولايات الأمريكية […]
سرطان الخلايا الحرشفية في البلعوم
سرطان الخلايا الحرشفية في البلعوم هو أحد أشهر أنواع السرطان التي تصيب منطقة البلعوم، والتي تشمل الحنجرة واللوزتين وقاعدة اللسان والأوتار الصوتية، وفي أغلب الحالات، […]

سرطان الخلايا الحرشفية في الحنجرة
يعد سرطان الخلايا الحرشفية في الحنجرة أحد أنواع السرطانات الخطيرة التي تصيب الحنجرة، والذي يبرز التدخين وتعاطي الكحول كأهم أسبابه، ويؤثر هذا المرض على قدرة […]

سرطان الخلايا الحرشفية في المريء
سرطان الخلايا الحرشفية في المريء هو نوع من الأورام التي تنتشر في الخلايا التي تبطن الجزء العلوي من المريء، وينتشر هذا النوع من السرطان بكثرة […]

سرطان الخلايا الحرشفية | دليلك الشامل
سرطان الخلايا الحرشفية من أكثر الأنواع الشائعة السرطانات التي تصيب الخلايا الرقيقة المسطحة التي تغطي الطبقة الخارجية للجلد، والتي تُعرف باسم الخلايا الحرشفية، يصاحب هذا […]

سرطان الخلايا الحرشفية في اللسان
سرطان الخلايا الحرشفية في اللسان Squamous Cell Carcinoma of the Tongue هو أحد أكثر أنواع سرطان الفم انتشارًا، ويبدأ في الظهور في الطبقة الخارجية للسان، […]
هل سرطان الخلايا الحرشفية خطير؟
سرطان الخلايا الحرشفية هي أحد أنواع سرطانات الجلد الشائعة، ويظهر هذا النوع من السرطان على الخلايا الرقيقة السطحية للبشرة، وفي هذا المقال سنجيب على بعض […]

سرطان الخلايا الحرشفية في عنق الرحم
توجد الكثير من أنواع السرطانات التي يمكن أن تصيب النساء، ولكن سرطان الخلايا الحرشفية في عنق الرحم هو أكثرها، وتزيد احتمالية الإصابة بذلك السرطان بين […]